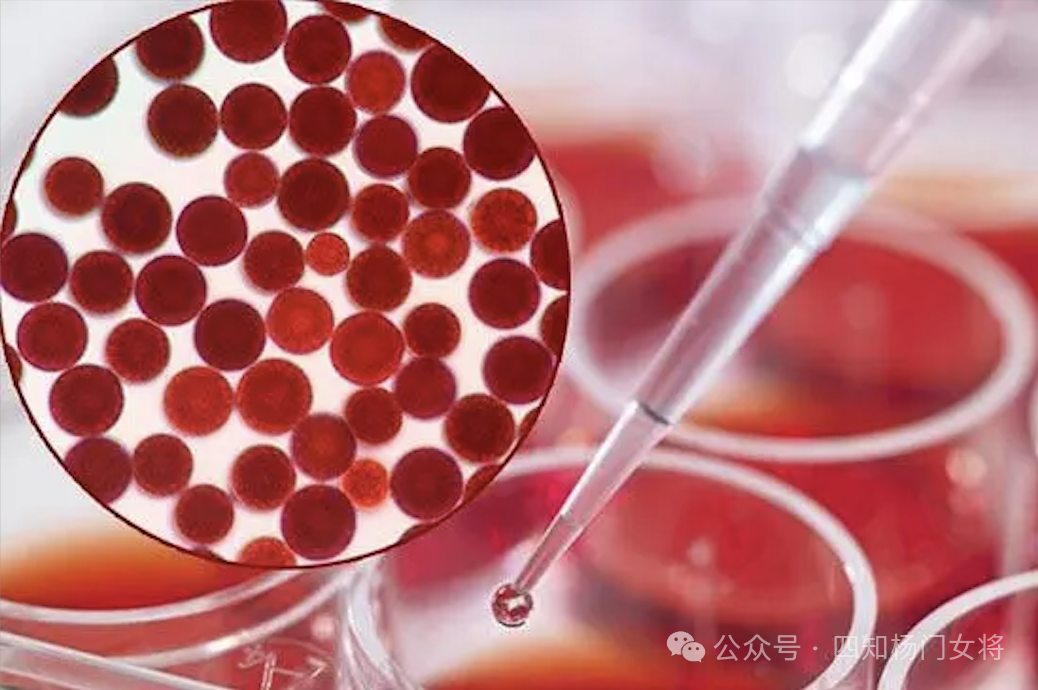
正常人补硒是多少毫克（补硒的正常量是多少）-硒宝网

正常人补硒是多少毫克(补硒的正常量是多少)
就现代人而言,吃肯定是导致肥胖的一个主要因素。试问,有谁又能够经受那些美食的诱惑呢,吃得过多之后又不爱运动,长久下去,脂肪就会在体内堆积,引发肥胖就是自然而然的事情了。

节食减肥是大多数人都喜欢的一种减肥方法,只要一狠心,一咬牙,把平时喜欢吃的火锅,烤肉戒掉就可以了,这样的减肥方法几天就会见到明显的效果,但问题是,这种减肥方法其实最不靠谱,对身体的危害非常之大,从短期来看,节食减肥可能会让体重降低,但只是一时的“假象”,恢复正常饮食后很快就会反弹,而且长期摄入热量过少,身体供能不足反而会造成一系列不良反应,不仅让你减肥失败还会危害身体健康。
因为节食时,我们摄入的热量不足,在血液中的糖原被用尽之后,身体为了维持各器官的正常运转,就会分解肝糖来供能,而肝糖原分解后会通过尿液的形式排出体外,身体分解1克肝糖原需要4克的水分,因此在节食初期体重下降,其实减少的大部分是体内大量的水分。
每天只吃很少的食物都可以引起身体脏器病变,更何况用水去代替食物呢?退一步来讲,减肥不是一个星期或者一个月的事,就算是去做抽脂手术瘦下来后也可以因为暴饮暴食而重新变成胖子,更何况节食减肥很可能会出现严重的体重反弹。

01
减肥是怎么回事?

首先我们要理解什么是减肥。我们之所以会肥胖,是因为我们需要通过充足的饮食来获取机体活动的能量,而这些能量含有大量的脂肪和糖分,以及其他营养元素,而我们需要利用体内各种催化酶的作用来分解和转变成这些食物。
因此,减肥的成功与否,其实取决于我们身体中酶的活性。而生成这些酶就需要大量的维生素、蛋白质、矿物质和微量元素等营养元素。如果你采用节食的方法来减肥,那样只会让自身的营养元素无法得到有效的补充。这就好比连必需的“助燃剂”都没有,脂肪又怎么“燃烧”呢?
硒是人体必需的微量元素,同时也是多种酶的活性中心,定量补硒可以提升人体中的血硒含量,激活各种酶的活性。从而增强机体对脂肪和糖分等营养元素的分解和利用。另外,硒还能帮助调节和增强其他维生素和微量元素的作用。而这些营养元素在发挥作用的同时,也能大大提升减肥的效率。
02
硒怎样达到
减肥的效果呢?

硒促进新陈代谢
从最简单的道理上讲,肥胖是人体能量摄入和消耗失衡的结果,即能量摄入大于能量消耗,结果造成能量在体内以脂肪的形式储存下来,经过一段时间后体重明显增加,最后形成肥胖。
而硒是人体必需的微量元素,中国营养学会也将硒列为人体必需的 15 种营养素之一,硒与其它微量元素、维生素具有协同作用,如硒与锌、铜及维生素 E、维生素 C、维生素 A、胡萝卜素等协同清除体内代谢废物——自由基,从而提高身体代谢率消耗脂肪,自然可以达到减肥的效果。
硒影响饮食行为
热量摄入过多,尤其是高脂肪饮食是造成肥胖病的主要原因。脂肪进入血液后,一部分通过氧化而供给身体活动所需要的热量。一部分作为细胞的组成部分,还有一部分转化为其他物质,多余的便进入脂库储存起来。如果吃得太多,机体所摄取的热量超过正常的消耗,食物中的脂肪进入脂肪库储存的数量就会增多,从而形成肥胖。
在酵素的作用下,生物才会有消化、呼吸、运动、生长、发育、繁殖等生命活动,才会产生新陈代谢等化学变化。硒元素能促进酵素活性,影响到酵素和激素运作,进而影响饮食行为,也就是说当硒元素不足时,可能发生异常旺盛的食欲,造成你暴饮暴食变胖。
硒养肠护胃
如果肠道问题严重,体内就会有吸收不了的残余,长期下来这些残余便会囤积在人体内导致变胖。此外,为了达到润肠通便减肥的功效,大多数减肥茶的原料对胃肠是有一定的刺激作用,过量了容易引起腹痛腹泻,反胃恶心等一系列肠胃问题。
而硒是有效的抗氧化剂,能够清除肠胃自由基清除肠胃毒素,修复肠胃受损细胞,让肠胃细胞充满健康活力,塑造健康有序的肠胃环境(无毒素、平衡肠胃酸性、肠胃功能运转正常、肠胃代谢正常、免疫力提高),从而促进胃黏膜的修复和肠胃溃疡的愈合,养护肠胃,?;こξ该馐芩鹕?/p>
硒能增强免疫,让人更有体力减肥
由于”硒”的高抗氧化作用,适量补充能起到防止器官老化与病变,延缓衰老,增强免疫,抵御疾病,抵抗有毒害重金属,减轻放化疗副作用,防癌抗癌。
硒能清除体内自由基,排除体内毒素、抗氧化、能有效的抑制过氧化脂质的产生,防止血凝块,清除胆固醇,增强人体免疫功能,令体内机能正常运作的同时不会消耗多余的能量,消除疲劳,让你更有体力去进行各种运动减肥,饮食与运动相结合,自然瘦得更快。

植物富硒片,是以安康天然种植的堇叶碎米荠为主要原料精制而成的——天然补硒珍品。
每片含硒50微克,有机硒检测达99.6%。
成人每天咀嚼或冲服1~2片即达补硒效果。

安康,被国内外权威专家称之为“优质、环保、安全”的富硒地区,被誉为“世界硒源”、“中国硒谷”。
堇叶碎米荠,俗称野油菜。2021年3月,国家卫健委批准为可参照叶菜类蔬菜标准管理的新资源食品。由于该植物具有超强的聚硒能力,被专家称之为“聚硒之王”。因其立地条件要求很高,种植难度很大,全国鲜有种植成功者。
本公司开始引进试种,历经坎坷,终获成功,最大种植面积达到300亩。
据多家检测机构检测,在我市富硒土壤天然种植的堇叶碎米荠,每千克硒含量达250毫克,即每克250微克,为其他植物的2000倍左右,且99%以上为有机硒。

